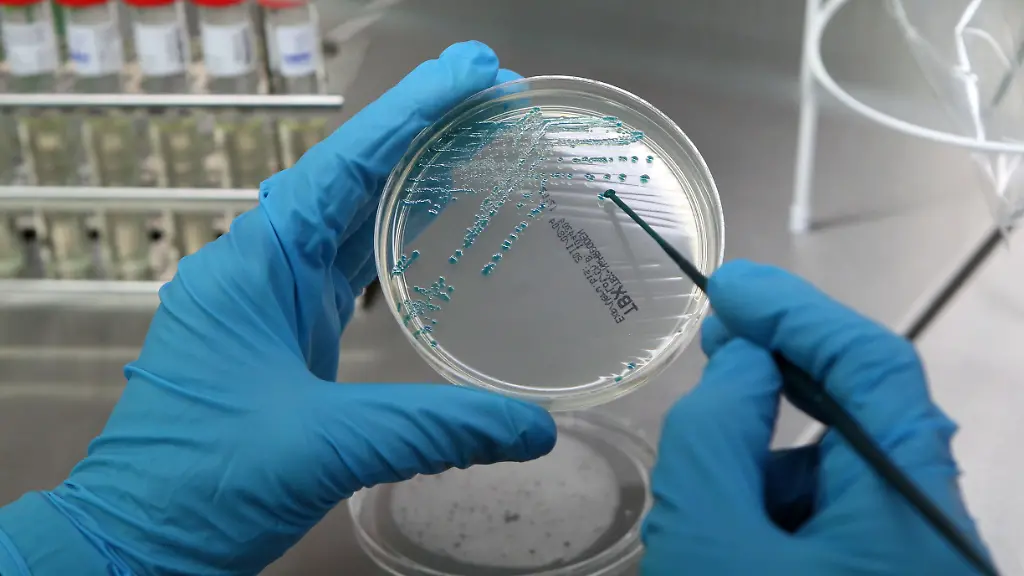
30960952

Wettrüsten ums ÜberlebenMensch gegen Mikrobe
Durch den Masseneinsatz von Antibiotika entwickeln immer mehr Bakterien Multiresistenzen. Diese Superkeime sind mit zur Verfügung stehenden Medikamenten praktisch nicht mehr zu behandeln. Eine Gen-Waffe aus den USA weckt nun Hoffnungen.
Die Erforschung und Anwendung von Antibiotika stellt eine Zäsur in der Geschichte der Medizin dar. Die Entdeckung der antibakteriellen Wirkung bestimmter Schimmelpilze wie des Penicillium chrysogenum war die Geburtsstunde einer Wunderwaffe gegen bis dato tödliche Infektionskrankheiten. Cholera, Tuberkulose und anderen bakteriellen Atemwegserkrankungen, bis zur ersten Hälfte des 20. Jahrhunderts noch die großen Geißeln der Menschheit, war mit einem Schlag der Schrecken genommen.
Lag die durchschnittliche Lebenserwartung in Deutschland 1910 noch bei 49 Jahren, stieg sie nach Einführung des Penicillins innerhalb von 20 Jahren auf 61. Heutzutage werden die Menschen im Durchschnitt sogar rund 30 Jahre älter als vor der Entdeckung des Bakterienkillers. Zwar sorgten auch andere Umstände wie eine gestiegene Hygiene, bessere Ernährung sowie der medizinische Fortschritt insgesamt für ein längeres Leben. Doch kein Einzelaspekt hatte einen derart starken Einfluss auf den Anstieg der Lebenserwartung wie der medizinische Einsatz von Antibiotika.
Fluch der Effektivität
Die Effektivität von Penicillin und seinen Folgepräparaten hat allerdings auch seine Schattenseiten. Oft wird unkritisch und viel zu leichtfertig nach den vermeintlichen Alleskönnern gegriffen. Antibiotika gehören inzwischen zu den am häufigsten verschriebenen Medikamenten weltweit. In Deutschland haben im Jahre 2010 21,9 Millionen Patienten, beinahe ein Drittel aller hierzulande gesetzlich Krankenversicherten, Antibiotika verordnet bekommen. Hinzu kommt der flächendeckende Einsatz von Antibiotika in der Massentierhaltung. Beinahe die Hälfte der weltweit produzierten Antibiotika wird in der Viehzucht verwendet. Der unbedachte Einsatz der medizinischen Wunderwaffe führt dazu, dass das einst so scharfe Schwert im Kampf gegen gesundheitsschädliche Bakterien stumpf wird.
In den letzten Jahren entwickeln und verbreiten sich multiresistente Erreger mit alarmierender Geschwindigkeit. Die WHO bezeichnet sie in einem Bericht zu dem Thema als "eine der Hauptgefahren für die Gesundheit" und warnt vor einer "Nach-Antibiotika-Ära", in der selbst "simple Infektionskrankheiten" wieder töten könnten. Hochresistente Erreger wie MRSA oder ESBL-Bakterien sind bereits soweit mutiert, dass sie mit den zur Verfügung stehenden Antibiotika praktisch nicht mehr in Schach gehalten werden können.
Trotz des drängenden Problems ist der Nachschub an neuen Antibiotika-Präparaten seit Anfang des neuen Jahrtausends ins Stocken geraten. Der Pharmariese Pfizer hat bereits 2011 seine Forschungseinrichtung im englischen Sandwich geschlossen und das Zentrallabor in Groton im US-Bundesstaat Connecticut eingeschrumpft. Auch Hoffmann-La Roche, Johnson & Johnson und Eli Lilly haben sich aus der Entwicklung neuer Antibiotika verabschiedet oder ihre Bemühungen gedrosselt.
Anreize fehlen
Die Entwicklung neuer Antibiotikapräparate ist für die Pharmakonzerne aus mehreren Gründen nicht lukrativ genug. Gestiegene Hürden bei der Zulassung, kurze Einnahme-Zeiten und damit vergleichsweise geringe Einkünfte sowie eine hohe Abnutzungsgefahr durch Resistenzen lassen die Investition in Erforschung und Entwicklung neuer Präparate wenig attraktiv erscheinen. Mit Medikamenten gegen chronische oder langwierige Erkrankungen lässt sich wesentlich mehr Geld verdienen. Die Infectious Diseases Society of America warnt schon seit Längerem vor einem Marktversagen.
"Künftig neue Antibiotika zu entwickeln, kann nicht mehr nach dem bewährten System geschehen", ist Ingrid M. Hack vom Bundesministerium für wirtschaftliche Zusammenarbeit und Entwicklung (BMZ) überzeugt. Gemeinsam mit Dr. Till F. Schäberle vom Institut für Pharmazeutische Biologie der Universität Bonn fordert sie in einem Beitrag für das renommierte Fachjournal "Trends in Microbiology" Pharmaindustrie und Politik zum schnellen Handeln auf. Gewünscht ist eine verstärkte Zusammenarbeit zwischen Wissenschaft, Industrie und Regierungen in Form einer Public Private Partnership.
Jagd per DNA-Steckbrief
Vor allem von der Genomforschung erhoffen sich Experten Lösungen für das Problem der sich ausbreitenden multiresistenten Keime. Einer neuen Studie zufolge könnte der erste Schritt in die richtige Richtung bereits getan sein. Wie Timothy Lu vom Massachusetts Institute of Technology (MIT) und seine Kollegen in der Fachzeitschrift "Nature Biotechnology" darlegen, ist es ihnen gelungen, die genetischen Grundlagen für Resistenzen bei Bakterien als Markierungen für gezielte Tötungen bestimmter Erregerpopulationen zu nutzen.
Bei dem vorgestellten Verfahren wird mithilfe des CRISPR/Cas-Systems (siehe Infobox oben) Jagd auf bestimmte DNA-Abschnitte gemacht, die mit den Antibiotikaresistenzen der Keime in Zusammenhang stehen. Das Verfahren ist vom bakterieneigenen Abwehrmechanismus abgeschaut. Krankenhauskeime wie MRSA könnten somit schon bald mit ihren eigenen Waffen geschlagen werden. Momentan wird die Methode noch an Mäusen getestet - bis zum Einsatz am Menschen ist es noch ein weiter Weg.
Doch auch wenn neue Behandlungsmethoden etabliert werden, besteht immer die Gefahr einer erneuten Anpassung der extrem wandlungsfähigen Erreger. Die Suche nach neuen Wirkstoffen dient letzten Endes nur der Aufrechterhaltung des Status Quo. Das Wettrüsten zwischen Wirt und Parasit geht weiter.